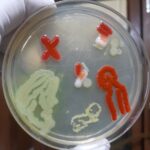
Human Microbiome Agar Art and its Importance in our body

Tag: Agar Art
Human Microbiome: Agar Art
Human Microbiome ‘Human Microbiome’ is an abstracted artwork of the...
Human Microbiome ‘Human Microbiome’ is an abstracted artwork of the...
Microbial Art: Introduction, Requirements, Making Procedure, Uses and Keynotes
 Introduction of Microbial Art Agar art or microbial art or...
Introduction of Microbial Art Agar art or microbial art or...
Agar Art with Living Microbes: Introduction, Requirements, Making Procedure and Application
 Introduction of Agar Art with Living Microbes Agar art or...
Introduction of Agar Art with Living Microbes Agar art or...
